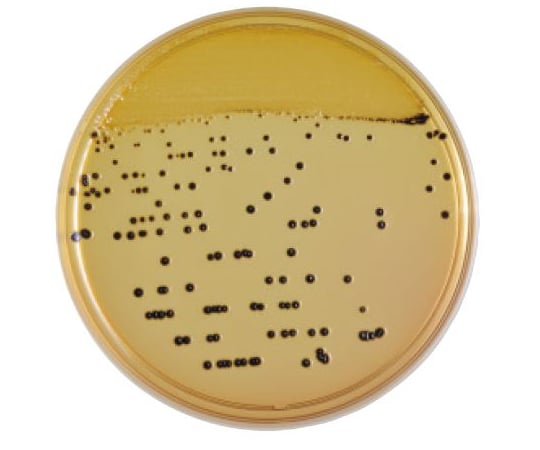

Similar to 光栄養細菌

光合成細菌
Phototrophic prokaryotes
BSJ複合菌

O抗原

亜硝酸菌
Nitrifying bacteria
硫黄細菌
Sulfur-reducing bacteria
衛星現象

SIM培地

LIM培地
桿菌
Bacillus (shape)莢膜
Bacterial capsule
グラム陽性菌
Gram-positive bacteria
好アルカリ菌
Alkaliphile
酢酸菌
Acetobacteraceae
硝酸菌

チョコレート寒天培地
Chocolate agarDHL寒天培地

鉄バクテリア
Iron-oxidizing bacteria
日本細菌学会

バクテリオシン
Bacteriocin
溶菌
Lysis
酪酸菌

アギトコッカス属
Agitococcus
AGS寒天培地

10-ホルミルテトラヒドロ葉酸
10-Formyltetrahydrofolate
1048576
1048576
1960年ローマオリンピックのバスケットボール競技・男子日本選手団

1960年ローマオリンピックの日本選手団
Japan at the 1960 Summer Olympics
1964年東京オリンピックのバスケットボール競技・男子日本選手団